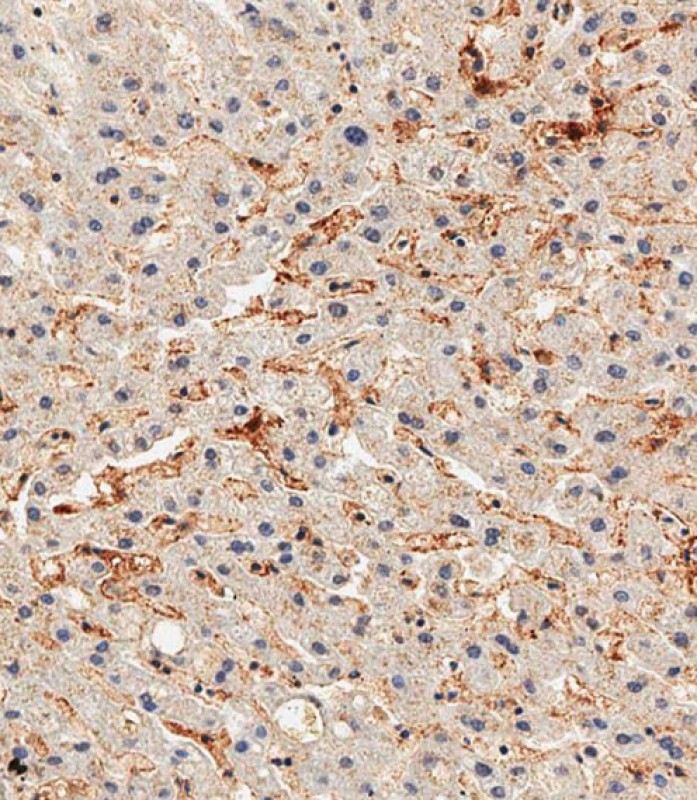
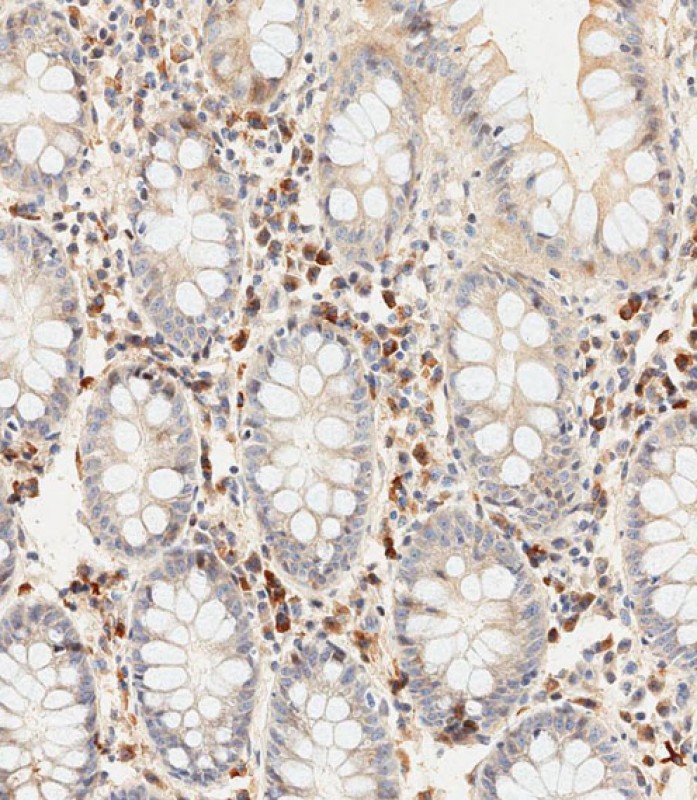

-
分类: 科研抗体货号: P34412别名: Discoidin domain-containing receptor 2, Discoidin domain receptor 2, CD167 antigen-like family member B, Neurotrophic tyrosine kinase, receptor-related 3, Receptor protein-tyrosine kinase TKT, Tyrosine-protein kinase TYRO10, CD167b, Ddr2, Ntrkr3, Tkt, Tyr应用: WB,IHC反应种属: Human, Mouse
-
分类: 科研抗体货号: P34427别名: Alkaline phosphatase, tissue-nonspecific isozyme, AP-TNAP, TNSALP, Alkaline phosphatase liver/bone/kidney isozyme, ALPL应用: WB,IHC反应种属: Human, Mouse, Rat
-
分类: 科研抗体货号: P34411别名: Hypoxia-inducible factor 1-alpha inhibitor, 1.14.11.30, 1.14.11.n4, Factor inhibiting HIF-1, FIH-1, Hypoxia-inducible factor asparagine hydroxylase, HIF1AN, FIH1应用: WB,IF反应种属: Human
-
分类: 科研抗体货号: P34426别名: Protein sel-1 homolog 3, Suppressor of lin-12-like protein 3, Sel-1L3, SEL1L3, KIAA0746应用: WB反应种属: Human
-
分类: 科研抗体货号: P34410别名: Multidrug resistance protein 3, 3.6.3.44, ATP-binding cassette sub-family B member 4, P-glycoprotein 3, ABCB4, MDR3, PGY3应用: WB反应种属: Human, Mouse, Rat
-
分类: 科研抗体货号: P34425别名: Ubiquitin thioesterase OTU1, DUBA-8, HIV-1-induced protease 7, HIN-7, HsHIN7, OTU domain-containing protein 2, YOD1, DUBA8, HIN7, OTUD2应用: WB,IHC反应种属: Human
-
分类: 科研抗体货号: P34409别名: Cytochrome c oxidase subunit 1, Cytochrome c oxidase polypeptide I, MT-CO1, COI, COXI, MTCO1应用: WB,IF反应种属: Human, Mouse, Rat
-
分类: 科研抗体货号: P34424别名: Visinin-like protein 1, VILIP, VLP-1, Hippocalcin-like protein 3, HLP3, VSNL1, VISL1应用: WB反应种属: Human, Mouse, Rat
-
分类: 科研抗体货号: P34408别名: Transcription factor E2F5, E2F-5, E2F5应用: WB反应种属: Human, Mouse, Rat
-
分类: 科研抗体货号: P34423别名: Protein lin-28 homolog B, Lin-28B, LIN28B, CSDD2应用: WB反应种属: Human, Mouse

鄂公网安备42018502007531号
鄂公网安备42018502007531号

